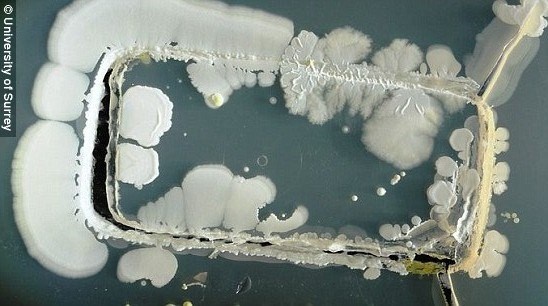

Theo các chuyên gia y tế Anh, chiếc điện thoại không tự tạo ra vi khuẩn mà thủ phạm chính là đôi tay chúng ta. Bàn tay, ngón tay là bộ phận làm việc nhiều nhất trong cơ thể con người, nhiều hơn cả não, do đó tiếp xúc nhiều nhất với các dụng cụ, vật phẩm chứa vi khuẩn và vô tình đưa chúng vào cơ thể.
Chiếc điện thoại di động thông minh, tiện ích lại chứa vô số vi khuẩn gây cảm cúm, đau mắt đỏ, ho… thậm chí là vi khuẩn E. coli và Staphylococcus aureus.